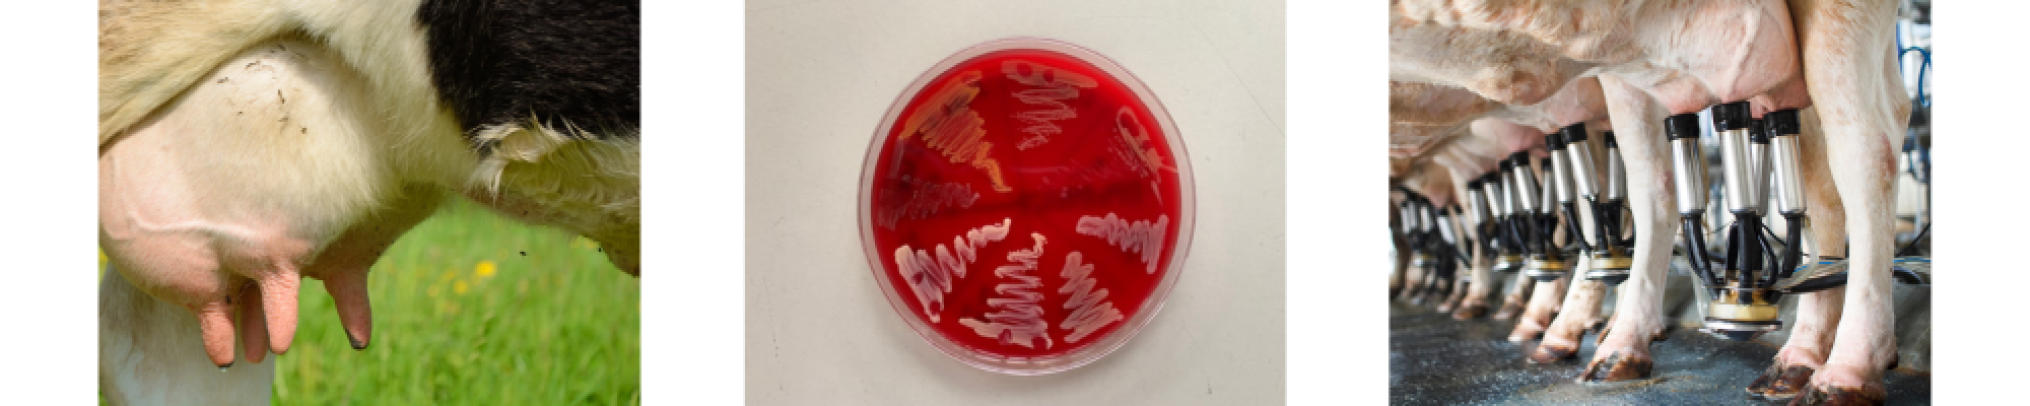
Webinar 'Selectief behandelen van niet-ernstige klinische mastitis"

Webinar 'Selectief behandelen van niet-ernstige klinische mastitis"
https://www.rundveeloket.be/agenda/webinar_selectief-behandelen-klinische-mastitis
Webinar Selectief behandelen van niet-ernstige klinische mastitis
Praktisch
Wanneer? Woensdag 26 november, 13u - 14u
Waar? Online (via Microsoft Teams)
On Practice Culture
Gedurende 2 jaar onderzochten we op verschillende Vlaamse melkveebedrijven het selectief behandelen van niet-ernstige klinische mastitis. Wat leerde deze praktijkproef en hoe kan je hiermee aan de slag als dierenarts, melkveehouder of adviseur? In deze webinar gaan we dieper in op de resultaten van de veldproef en krijg je concrete tips en inzichten om de melkroutine te optimaliseren. Met een correcte melktechniek en zorgvuldige opvolging van mastitis-gevallen maak je immers werk van een betere uiergezondheid! Meer info project 'On Practice Culture'
Programma
13u00: Inleiding en kadering project (Prof. dr. Sarne De Vliegher, UGent)
13u05: Selectief behandelen op Vlaamse bodem (Drs. Lien Creytens, UGent)
13u35: Ervaringen uit de melkput (Dr. Zyncke Lipkens, MCC)

